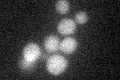
YMR090W
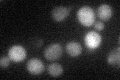
YMR090W

View description
Putative protein of unknown function with similarity to DTDP-glucose 4,6-dehydratases; GFP-fusion protein localizes to the cytoplasm; up-regulated in response to the fungicide mancozeb; not essential for viability
Localization:
Intensity:
Fold change:
Significance:
-
C’ GFP library in SD
cytosol26.45 -
N' NOP1pr-GFP in SD

cytosol334.692 -
N' TEF2pr-mCherry in SD

cytosol193.081 -
N' NATIVEpr-GFP in SD

cytosol38.6562 -
N' TEF2pr-VC and Cyto-VN in SD

cytosol80.6316 -
C’ GFP library in SD+DTT

cytosol371.39Yes -
C’ GFP library in SD+H2O2
cytosol19.840.75No -
C’ GFP library in Starvation Media

cytosol79.122.99Yes -
C’ GFP library on the background of Pup2-DaMP

cytosol -
C’ GFP library on the background of CCT mutant

cytosol28.11581.0627No
